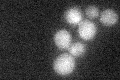
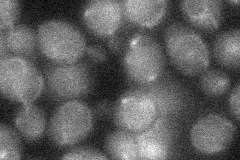
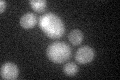
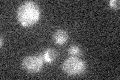

View description
Cyclin, interacts with cyclin-dependent kinase Pho85p; member of the Pcl1,2-like subfamily, involved in the regulation of polarized growth and morphogenesis and progression through the cell cycle; localizes to sites of polarized cell growth
Localization:
Intensity:
Fold change:
Significance:
-
C’ GFP library in SD
below threshold17.32 -
N' NOP1pr-GFP in SD

below threshold16.9071 -
N' TEF2pr-mCherry in SD

below thresholdN/A -
N' NATIVEpr-GFP in SD

below threshold19.9012 -
N' TEF2pr-VC and Cyto-VN in SD
below threshold21.7075 -
C’ GFP library in SD+DTT
cytosol16.510.95No -
C’ GFP library in SD+H2O2

cytosol16.950.97No -
C’ GFP library in Starvation Media
cytosol16.620.95No -
C’ GFP library on the background of Pup2-DaMP

N/A -
C’ GFP library on the background of CCT mutant

N/A0N/AYes
